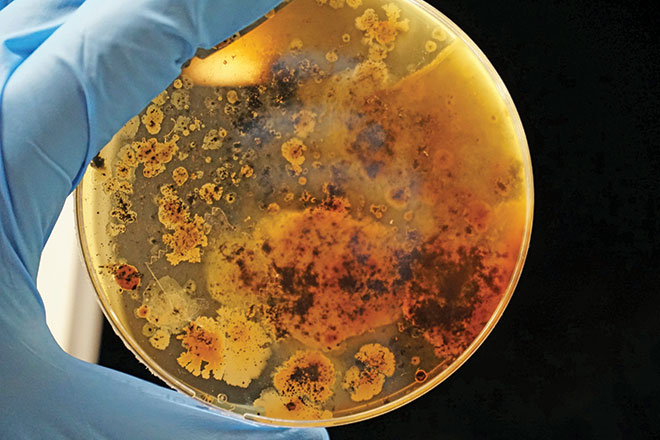
660px-2.-adrian-lange-Wk902ZLaA7M-unsplash meat

ABOVE: The report revealed the presence of multi-antibiotic resistant bacteria in chicken and pork meat sold in Australian supermarkets
New research highlighted recently on ABC’s 7.30 Report revealed the presence of multi-antibiotic resistant bacteria in chicken and pork meat sold in Australian supermarkets.
The most alarming discovery was bacteria harbouring three different variants of a gene conferring resistance to the antibiotic Colistin – a life-saving drug of last resort for the most severe infections that have proven to be multi-drug resistant in hospital patients.
Animals Australia commissioned the University of Canberra’s Host-Microbe Interactions Research Group to examine the level of antimicrobial resistant bacteria in chicken and pork meat sold by Australia’s four major supermarket chains.
University of Canberra biomedical science associate professor Dr Claire O’Brien said, “This study revealed that a diverse array of bacterial species can be isolated from retail chicken and pork meat and includes some of the leading pathogenic bacteria in humans, including e coli, which is capable of causing serious infections.”
“It shows that Australia is not immune to the global spread of antimicrobial genes, and better surveillance and prevention is more pressing than ever.”
Samples of 244 raw packaged chicken and 160 raw packaged pork meat were obtained from Aldi, Coles, IGA and Woolworths stores across metropolitan and regional NSW and the ACT, many of which were then selected for whole genome sequencing and testing.

Included in the research findings were that 33 types of bacterial species that cause infection in humans were found in the meat samples. Photo: Drew Hays
Among the key findings of the research study:
- 33 types of bacterial species that cause infection in humans were found in the meat samples
- All the bacterial species showed resistance to at least one class of antibiotics that are classified as critically or highly important by the World Health Organisation
- 12 percent of the bacteria species found had multi-drug resistance to antibiotics used in human medicine – ‘superbugs’.
Animals Australia legal counsel Shatha Hamade said, “The results of this study confirm the seriousness of this situation.”
“Currently, public awareness is close to zero.
“People are buying chicken and pork products completely oblivious of related antibiotic-resistant concerns.
“Australia is trailing other developed nations in acting on this issue of global concern.
“Consumers trust that food in supermarkets will have been subjected to the most stringent regulation and checks to ensure its safety,” Ms Hamade said.
Currently, that is not the case
“Over the past 50 years, animal industries have commodified sentient beings and ignored their needs and well-being in favour of profit and productivity.”
“We cannot treat other forms of life so appallingly without there also being repercussions for humanity as well,” she said.
This research follows a 2022 report from the Monash University Centre to Impact AMR, commissioned by World Animal Protection, which found an alarming proportion of antimicrobial resistant bacteria in raw packaged beef and salmon from Australian supermarkets.
World Animal Protection campaign manager Rochelle Flood said, “Once again this raises serious questions about how and how many antibiotics are used by the Australian livestock industry, and it reinforces the urgent need for a comprehensive monitoring and reporting program for antimicrobial use and resistance.”
“Australians have the right to know what’s in our food and whether it is potentially putting our health at risk.
“As the CSIRO has warned, if we don’t address the rise of antimicrobial resistance we risk returning to the dark ages of medicine where common infections kill and surgery becomes inherently risky.
“We cannot let this happen,” Ms Flood said.
Currently in Australia, antibiotics can be given to groups of animals with no diagnosed illness as way to prevent disease.
This sometimes occurs in low-welfare settings where animals are kept in poor conditions or handled in ways which can lead to disease.
The European Union has banned this practice and there are calls for Australia to follow suit.
Animals Australia and World Animal Protection are calling for the federal and state governments to introduce mandatory public reporting of antibiotic use across the animal agriculture sector, as is common in many other countries.
The two organisations are also calling for a ban on the use of antibiotics for growth promotion and for routine disease prevention.
Antibiotics should be reserved for the treatment of animals with a diagnosed illness, they should not be relied on as a way to prevent disease.
Instead, industry should work to maximise welfare conditions to limit the risk of illness and disease.